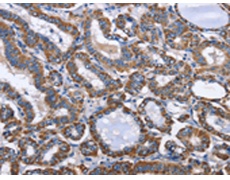
一抗

|
Background: |
INTS1 is a subunit of the Integrator complex, which associates with the C-terminal domain of RNA polymerase II large subunit and mediates 3-prime end processing of small nuclear RNAs U1 and U2. RNA polymerase II (Pol II) is an enzyme that is composed of twelve subunits and is responsible for the transcription of protein-coding genes. Transcription initiation requires Pol II-mediated recruitment of transcription machinery to a target promoter, thereby allowing transcription to begin. |
|
Applications: |
ELISA, IHC |
|
Name of antibody: |
INTS1 |
|
Immunogen: |
Synthetic peptide of human INTS1 |
|
Full name: |
integrator complex subunit 1 |
|
Synonyms: |
INT1; NET28 |
|
SwissProt: |
Q8N201 |
|
ELISA Recommended dilution: |
2000-5000 |
|
IHC positive control: |
Human brain |
|
IHC Recommend dilution: |
25-100 |

 購物車
購物車 幫助
幫助
 021-54845833/15800441009
021-54845833/15800441009